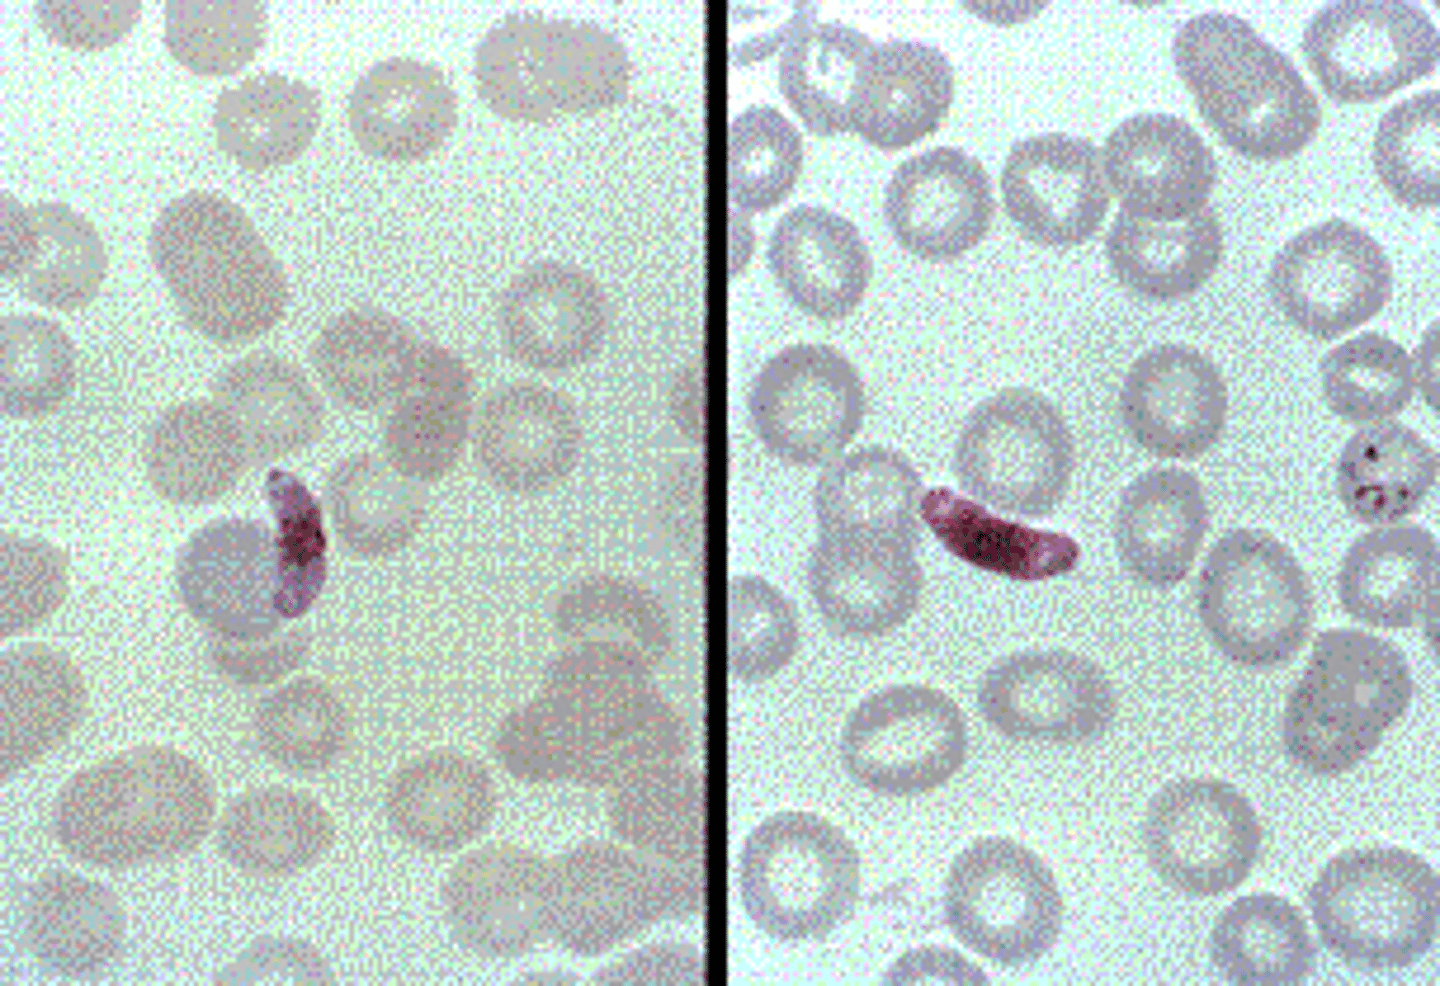
<p>c.P. falciparum.</p><p>P. falciparum invades RBCs of any age and, for this reason, often exhibits the highest parasitemia—reaching 50% in some cases. The ring forms of P. falciparum are more delicate than those of other species, often have two chromatin dots, and may show multiple ring forms in a single RBC. Gametocytes have a characteristic banana or crescent shape. </p>
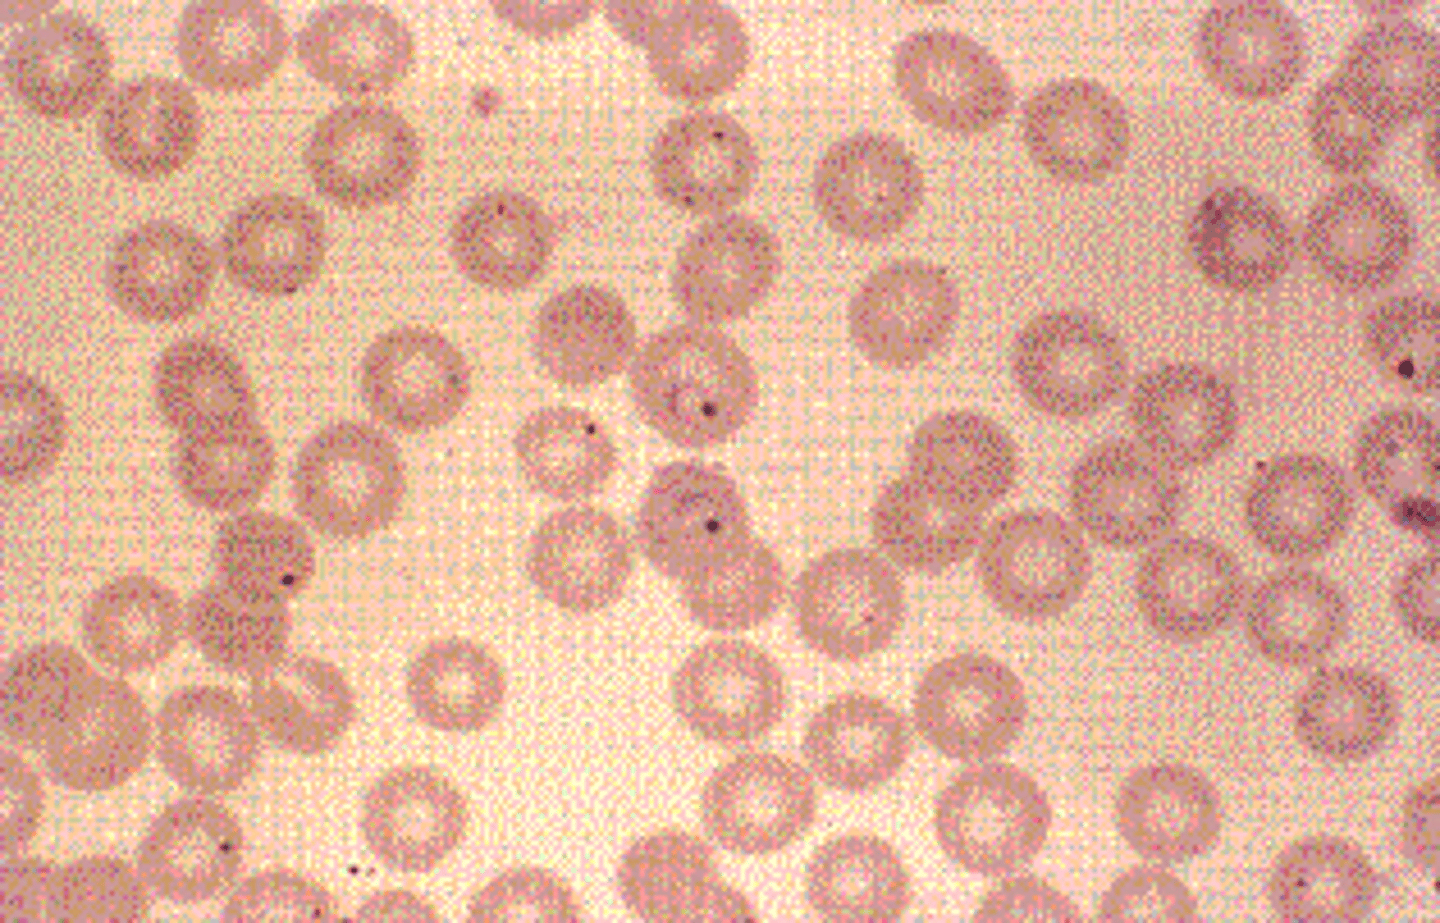
<p>d.P. vivax.</p><p>P. vivax has the widest geographic distribution and is the one most likely to be found in temperate climates. A fine pink stippling, known as Schüffner’s stippling, may be present in the cell. The young trophozoite of P. vivax is characterized by its ameboid appearance; by maturity, it usually fills the RBC, and golden brown malarial pigment is present.</p>

1/20
Looks like no tags are added yet.
Name | Mastery | Learn | Test | Matching | Spaced | Call with Kai |
|---|
No study sessions yet.
A 4-year-old child has been complaining of a stomachache and has had intermittent episodes of diarrhea. Physical examination reveals an apparently healthy child with a mildly distended abdomen. Because of the diarrhea, a fecal sample is sent for culture and for ova and parasites examination. What is the identity of that found at 400× in the child’s fecal sample?
Select one:
a.Ascaris lumbricoides
b.Strongyloides stercoralis
c.Hookworm
d.Schistosoma haematobium
a.Ascaris lumbricoides
The usual diagnostic stage is the egg. Fertile Ascaris eggs are oval, measure 45 to 75 μm by 35 to 50 μm, and have thick hyaline walls surrounding a one-cell-stage embryo. Most eggs have a brown, bile-stained mammillated outer layer, not seen in this image

The following organism was found at 1000×in the fecal sample of a patient with fever and diarrhea. This organism is most likely:
Select one:
a.Entamoeba histolytica
b.E. hartmanni
c.Giardia lamblia
d.E. coli
a.Entamoeba histolytica
The size of the organism ranges from 10 to 50 μm, averaging 15 to 25 μm. The organism is refractile, and the characteristic “bull’s-eye” nucleus, consisting of a small central karyosome. Even, fine peripheral chromatin may be only slightly visible. The average size of the E. histolytica cyst is 10 to 20 μm and may have one to four nuclei each with a small central karyosome and fine, evenly distributed peripheral chromatin.

A patient who has traveled to Puerto Rico comes to a clinic with a history of diarrhea for the past 2 weeks. A fecal sample collected for O&P shows the following parasite at 400×. This organism is most likely
Select one:
a.Schistosoma mansoni.
b.S. japonicum.
c.S. haematobium.
d.S. madurella.
a.Schistosoma mansoni.
S. mansoni, which is most commonly found in Africa, parts of South America, the West Indies, and Puerto Rico, lives in venules of the mesentery and large intestines. The egg of S. mansoni is yellowish, elongated and 115 to 175 μm by 45 to 75 μm, and has a prominent lateral spine.

A patient with recent history of travel to the Philippines has bloody diarrhea. An ova and parasites examination of the stool shows the following at 400×.
Select one:
a.Schistosoma mansoni
b.S. japonicum
c.S. haematobium
d.S. madurella
b.S. japonicum
S. japonicum, which is commonly found in the Far East, including Japan, China, and the Philippines, lives in venules of the small intestine. The egg spines cause trauma to the tissues and walls of the vessels during the early stage of acute infections and can result in diarrhea. S. japonicum eggs are round and 60 to 95 μm by 40 to 60 μm; they have a small, curved, rudimentary spine.

A woman who just returned from a trip to Southeast Asia has signs of biliary obstruction, which is confirmed by CT scan. Due to her recent travel history, the physician orders an ova and parasites examination before considering surgical intervention. The following element is found in her fecal sample at 400×. The most likely identity of this organism is
Select one:
a.Schistosoma mansoni.
b.Clonorchissinensis.
c.Fasciola hepatica.
d.Heterophyes heterophyes.
b.Clonorchissinensis.
The Chinese liver fluke, Clonorchis (Opisthorchis) sinensis, is geographically limited to the Far East, where dogs and cats serve as reservoir hosts. The adults live in the distal bile ducts. Repeated or heavy infections cause inflammation because of mechanical irritation, fever, diarrhea, pain, fibrotic changes, or obstruction of the bile duct. The diagnosis is made by finding the egg in a stool specimen. The egg is 29 to 35 μm long, embryonated when passed, flash shaped, and operculated with prominent shoulders at the operculum and a knob at the opposite end.

A patient finds a small ribbonlike object in his stool and reports this to his physician. The physician orders a fecal ova and parasite analysis that reveals the following egg in the sample at 400×. The most likely identity of this parasite is
Select one:
a.Hymenolepis nana.
b.Taenia spp.
c.Diphyllobothrium latum.
d.Paragonimus westermani.
b.Taenia spp.
Laboratory diagnosis of Taenia spp. infection can be made by finding the egg, scolex, or proglottid in the feces. The egg is yellow-brown and surrounded by a thick wall with radial striations; it measures 30 to 43 μm. The egg is embryonated with a six-hook oncosphere when passed in the feces. Eggs of this species are indistinguishable and must be reported as “Taenia spp.” eggs.

A patient with a history of eating wild game comes to the physician with a history of diarrhea over the past 3 weeks. In addition, he complains of fever, muscular pain and tenderness, headache, and general weakness. The patient also has a significant eosinophilia. A biopsy of a nodular area on his forearm is seen in the image below. This is consistent with a diagnosis of infection caused by
Select one:
a.Leishmania donovani.
b.Wuchereria bancrofti.
c.Trichinella spiralis.
d.Loa loa.
c.Trichinella spiralis.
Trichinosis is the infection of muscle tissue with the larval form of T. spiralis, a helminth whose adult stages live in the human intestine. Humans acquire the infection by eating undercooked meat, particularly pork that contains the larval forms. In recent years ingestion of wild game has led to infection by other species of Trichinella. Because it is difficult to recover adults or larvae in a stool sample, the diagnosis is often based on clinical symptoms and the patient’s history. Biopsy of muscle tissue and identification of encapsulated, coiled larva is the definitive diagnostic method.

A farmer who raises sheep and cattle shows signs of jaundice. Along with elevated liver enzymes, he also has an elevated eosinophil count. A fecal sample for ova and parasites shows the parasite form seen below at 400×. The organism causing this infection is
Select one:
a.Paragonimus westermani
b.Heterophyes heterophyes
c.Schistosoma mansoni
d.Fasciola hepatica
d.Fasciola hepatica
Fasciola hepatica, the sheep liver fluke, is seen in the major sheep-raising areas of the world, including parts of the southwestern United States. In addition, the organism is found in some cattle-raising areas. The unembryonated and operculated eggs of Fasciola hepatica are carried in the bile to the intestinal tract and are passed in the feces. The size range is 130 to 150 μm by 60 to 90 μm. They are virtually indistinguishable from eggs of F. buski.

Five members of a family develop a sudden onset of watery diarrhea, nausea, vomiting, headache, and cramps. The family physician orders fecal cultures and complete ova and parasites analysis. Each sample reveals the presence of organisms seen below at 1000×. The most likely cause of the infection is
Select one:
a.Cryptosporidium parvum.
b.Isospora belli.
c.Cyclospora cayetanensis.
d.Encephalitozoon intestinalis.
a.Cryptosporidium parvum.
The recommended detection methods when Cryptosporidium infection is suspected are the modified Ziehl-Neelsen acid-fast stain and an immunofluorescent antibody test using a monoclonal antibody directed against Cryptosporidium. With the acid-fast stain, the organism stains as a bright red sphere that distinguishes it from yeasts, which stain green.

Identify the organism found in a peripheral blood thick smear at 1000×:
Select one:
a.Brugia malayi
b.Loa loa
c.Wuchereria bancrofti
d.Onchocerca volvulus
c.Wuchereria bancrofti
Diagnosis of W. bancrofti should include the examination of a blood specimen obtained at night (10 PM to 2 AM) for the presence of microfilariae. The blood may be examined immediately for live microfilariae. If examined on a Wright-stained smear, the microfilariae of W. bancrofti are sheathed, and the nuclei do not extend to the tip of the tail.

A young man from rural Brazil is visiting family in the United States when he becomes ill with muscle pains, high fever, and hepatosplenomegaly. A blood sample taken in the emergency department reveals the following organism at 1000×. The most likely identification of this organism is
Select one:
a.Leishmania donovani.
b.Babesia microti.
c.Plasmodium falciparum.
d.Trypanosoma cruzi.
d.Trypanosoma cruzi.
The primary diagnostic stage in the blood is the trypomastigote. It is an elongated structure 15 to 20 μm long that often appears in a C or U shape. Individuals in the acute phase may be asymptomatic or have local symptoms including the presence of a chagoma (ulcerative skin lesion at the site of the insect bite) or a unilateral edema around the eye (Romaña sign) if the bite is on the ocular conjunctiva. Systemic manifestations include fever, lymphadenitis, hepatosplenomegaly, malaise, muscular pains, and diarrhea and vomiting. The latent phase can last 10 to 40 years after infection, but only about 30% to 40% of patients develop the chronic form of Chagas disease.

A housewife from the Great Lakes area presents to her family physician with fatigue and malaise. Blood tests show that she has enlarged but pale RBCs (megaloblastic anemia) along with a vitamin B12 deficiency. Her history includes a dietary habit of making pickled fish, a family favorite. Because of this, an ova and parasites examination is also requested and reveals the following at 400×. What is the identity of this parasite?
Select one:
a.Hymenolepis nana
b.Taenia saginata
c.Diphyllobothrium latum
d.Taenia solium
c.Diphyllobothrium latum
D. latum, the fish tapeworm, is found worldwide in areas where the population eats pickled or raw fresh water fish. In the United States, it is primarily seen in the areas around the Great Lakes. The organism may cause a vitamin B12 deficiency, especially in persons of northern European descent, and long-term infection can lead to a megaloblastic anemia. The egg is operculated and yellow-brown, about 58 to 76 μm by 40 to 50 μm and has a small, knoblike protuberance at the end opposite the operculum

A woman patient with history of travel to tropical Africa was noncompliant with her antimalarial medications. She now has a cyclical fever and paroxysm every 72 hours. The following organism is seen in her peripheral blood smear at 1000×is consistent with an infection caused by
Select one:
a.Plasmodium ovale.
b.P. vivax.
c.P. falciparum.
d.P. malariae.
d.P. malariae.
Plasmodium malariae usually invades older RBCs, perhaps accounting for the occasional darker appearance of the invaded RBC. The life cycle is characterized as quartan, with reproduction occurring every 72 hours and invasion of new RBCs every fourth day. The trophozoite of P. malariae is compact and may assume a characteristic “band” appearance, in which it stretches across the diameter of the RBCs. The mature schizont contains 6 to 12 merozoites with an average of 8. Merozoites may be arranged in a characteristic loose daisy petal arrangement around the clumped pigment as seen in this image.

A recent emigrant from Somalia develops high fever, chills, and severe headache. Blood work on admission to the hospital reveals the following in his blood smear at 1000×. This patient is most likely infected with
Select one:
a.Plasmodium ovale.
b.P. malariae.
c.P. falciparum.
d.P. vivax.
c.P. falciparum.
P. falciparum invades RBCs of any age and, for this reason, often exhibits the highest parasitemia—reaching 50% in some cases. The ring forms of P. falciparum are more delicate than those of other species, often have two chromatin dots, and may show multiple ring forms in a single RBC. Gametocytes have a characteristic banana or crescent shape.
A 15-year-old boy spent most of the summer at the northern Minnesota family cabin on a lake in a densely wooded area. After returning to school in the fall, he was frequently tired and listless with periods of fever and chills. A blood sample revealed the following organism at 1000×. The most likely identification is
Select one:
a.Plasmodium ovale.
b.Babesia microti.
c.Plasmodium malariae.
d.Trypanosoma cruzi.
b.Babesia microti.
The diagnosis of babesiosis is made from a Wright-Giemsa-stained thin blood smear. The organisms appear as small, delicate, ring-form trophozoites, about 1 to 2 μm, with a prominent chromatin dot and faintly staining cytoplasm. More mature trophozoites may appear as pyriform organisms in single, double, or the classic tetrad (Maltese cross) formation within the red blood cells (RBCs).

Several children at a daycare center are having trouble sleeping and are showing increasing signs of restlessness. Because one child was recently diagnosed with an intestinal parasite, the parents are informed that other children should be tested. The organism below is found at 400× during examination. This organism is
Select one:
a.Trichuris trichiura.
b.Enterobius vermicularis.
c.Ascaris lumbricoides.
d.Hookworm.
b.Enterobius vermicularis.
Enterobius vermicularis (pinworm) is a worldwide parasite commonly detected in children. Key risk factors for this infection are inadequate personal and/or community hygiene. The cellophane tape preparation is routinely used for detection of suspected pinworm infections. This procedure involves swabbing the child’s perianal area with a tongue blade covered with cellophane tape (sticky side out). The egg is oval, colorless, and slightly flattened on one side. It measures approximately 50 to 60 μm by 20 to 30 μm.

Some pathogens will not grow in culture and are usually unsuspected. This pathogen can be seen in the sputum and bronchoalveolar fluid of patients with a hyperinfestation syndrome. The name of this pathogen is
Select one:
a.Strongyloides stercoralis.
b.Giardia lamblia.
c.Treponema species.
d.Leptospira species.
a.Strongyloides stercoralis.
S. stercoralis is an intestinal nematode that goes through a stage of infection called larva migrans when the rhabditiform larvae travel through the walls of the intestines into the bloodstream and can be found in the lungs. Usually to diagnosis this disease, an ova and parasite examination on the patient’s stool is necessary.
A young man who returned a week ago from a family vacation to Kenya develops a high fever and delirium. Although he was compliant with his antimalarial medications, a blood sample is taken to rule out malaria. The laboratory scientist sees the following on the blood smear at 1000×. This organism is most likely
Select one:
a.Trypanosoma brucei.
b.Leishmania donovani.
c.Wuchereria bancrofti.
d.Loa loa.
a.Trypanosoma brucei.
Trypanosoma brucei rhodesiense and Trypanosoma brucei gambiense are the causative agents of human African trypanosomiasis, commonly called sleeping sickness, which is seen primarily in central Africa. The diagnostic stage of trypanosomes in humans is the trypomastigote, which is usually seen in a Wright-stained blood smear. The trypomastigote is 15 to 20 μm long, with a single large nucleus and a posterior kinetoplast to which is attached the flagellum of the undulating membrane.

When a request is submitted to examine a blood sample for malaria, which of the following procedures should be performed?
Select one:
a.A thick smear for maximum detection and to determine morphology
b.A PVA trichrome-stained blood smear
c.A Giemsa thick blood smear preparation for maximum detection and a thin smear for speciation
d.A formalin-ethyl acetate concentration for detection and a thin smear for speciation
c.A Giemsa thick blood smear preparation for maximum detection and a thin smear for speciation
History of travel to an endemic area and the presence of classic clinical symptoms, including the malarial paroxysm of fever and chills, should alert a health care provider to request Giemsa-stained thick and thin smears for malaria. The thick smear is used to detect malarial parasites (high sensitivity); however, distortions of parasite morphology and the lack of intact RBCs require that a thin smear be examined to identify the species.
An international male student from Egypt comes to the campus clinic complaining of blood in his urine. A urinalysis reveals the parasite seen below at 400×. This organism is
Select one:
a.Schistosoma mansoni.
b.S. japonicum.
c.S. haematobium.
d.S. madurella.
c.S. haematobium.
S. haematobium, which is primarily found in the Nile Valley, the Mideast, and East Africa, lives in the veins surrounding the bladder. Diagnosis is made by finding embryonated eggs in the urine. S. haematobium eggs are elongated and 110 to 170 μm by 40 to 70 μm, and have a terminal spine. The best time to collect the eggs in urinary schistosomiasis is during peak excretion time in early afternoon (12 PM to 2 PM).

A patient comes to the emergency department stating that he has fever and chills every 48 hours. The patient has a history of travel to Central America in the past month and did not take any preventative measures against malaria. A complete blood count shows the following RBC inclusions at 1000×. This organism is most likely
Select one:
a.Plasmodium malariae.
b.P. ovale.
c.P. falciparum.
d.P. vivax.
d.P. vivax.
P. vivax has the widest geographic distribution and is the one most likely to be found in temperate climates. A fine pink stippling, known as Schüffner’s stippling, may be present in the cell. The young trophozoite of P. vivax is characterized by its ameboid appearance; by maturity, it usually fills the RBC, and golden brown malarial pigment is present.